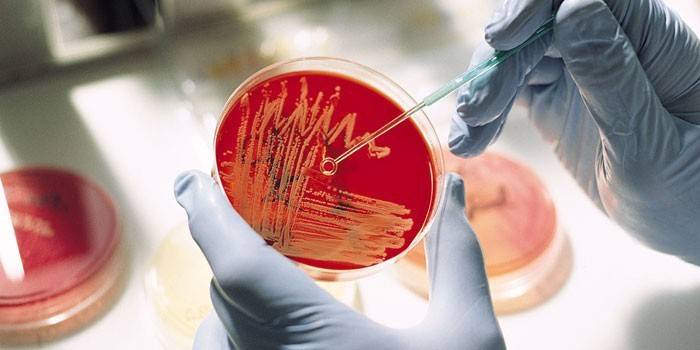

Análise de fungos nas unhas: preparação para o estudo
As infecções fúngicas são uma das doenças mais comuns da pele. A complexidade do tratamento desta doença está em uma ampla variedade de patógenos, que são virtualmente impossíveis de determinar visualmente. Uma análise do fungo ungueal por raspagem de uma placa, passando por uma análise de urina e sangue ajuda a estabelecer o tipo de micose e sua sensibilidade aos medicamentos. Para que os resultados do bioensaio sejam tão precisos quanto possível, o paciente deve ser cuidadosamente preparado.
O que é fungo nas unhas
Danos à placa ungueal devido à atividade de microrganismos parasitas é chamado de unha fungo. No processo de desenvolvimento da doença, a córnea fica amarela, começa a se romper e desmoronar e, na ausência de tratamento adequado, a onicomicose se espalha para as unhas e pele vizinhas, violando a imunidade celular. Quando os principais sinais de infecção aparecem, você precisa visitar um dermatologista, que irá prescrever uma série de testes clínicos e avaliar o estado da saúde humana.
Teste do fungo
Um estudo bioquímico permite ao médico determinar a presença e o tipo de micose nas camadas alteradas da unha. Com base nos resultados, ele será capaz de prescrever um curso eficaz de terapia medicamentosa. Depois de realizar um exame preliminar das áreas afetadas da pele, o médico encaminha o paciente para vários exames laboratoriais. Os seguintes métodos para diagnosticar onicomicose são:
- cultura microbiológica;
- Teste de PCR (reação em cadeia da polimerase) do sangue para determinar o DNA (ácido desoxirribonucleico) do parasita;
- análise geral de urina e sangue;
- raspando da unha para o fungo.
Preparação
Para que os parâmetros estudados não sejam distorcidos, um estágio preparatório é fornecido antes de passar pelo procedimento. Se um dermatologista duvidar dos resultados do teste, ele pode prescrever uma série de testes adicionais. Especialistas destacam vários pontos importantes que o paciente deve prestar atenção:
- Três dias antes de passar a análise microscópica, você não pode lavar o local de deslocamento de invasão fúngica.
- Não é recomendado cortar a placa ungueal 6-10 dias antes do próximo exame.
- É proibido aplicar quaisquer cremes, pomadas, vernizes ou cosméticos antifúngicos no local da infecção com uma infecção dentro de 3-4 dias antes do procedimento para a coleta de material biológico.
Como passar
Para diagnosticar a presença de uma infecção fúngica e o grau de infecção do corpo, são coletadas partículas da unha afetada. Para identificar doenças similares dos pés, os flocos epidérmicos são tomados no local proposto do desenvolvimento fúngico. A coleta de matérias-primas biológicas é um procedimento indolor. A análise de unhas para fungos ajuda a confirmar a natureza micótica da lesão, i.e. detectar cadeias de parasita. Para pesquisa em microscópio, um dos seguintes métodos é usado:
- as partículas da unha são tratadas com uma solução de sulfóxido de dimetilo, mantidas durante 5-15 minutos, depois observadas;
- tratado com hidróxido de potássio e armazenado por 24 horas a uma certa temperatura, após o qual o material é examinado.
Raspagem de fungos
Um teste de qualidade para o fungo é feito 3-5 dias. Os resultados do estudo contêm informações sobre a presença ou ausência de invasão. Se necessário, o tipo de patógeno, sua concentração, método de reprodução é estabelecido. A entrega do material para exame é realizada com um bisturi estéril de várias áreas da placa ungueal. Os resultados do teste só podem ser interpretados por um dermatologista que, após estudar o quadro clínico geral, prescreverá um medicamento adequado.
Exames de sangue
Juntamente com os métodos disponíveis para detectar a presença de infecção fúngica e determinar a sensibilidade desses microrganismos aos agentes antibacterianos, os médicos recomendam fazer um exame de sangue. É uma amostra de sangue de uma veia. O diagnóstico é realizado antes e depois do tratamento. No processo de pesquisa de laboratório, a presença de um parasita, o estágio de desenvolvimento da doença, o grau de infecção dos órgãos internos é determinado. As amostras podem ser colhidas na clínica de pele e venereologia ou em uma clínica particular em Moscou, que fornece o serviço adequado.
Urinálise
Para obter uma visão completa do curso da doença, o médico prescreve um exame geral de urina. Isso ajuda a eliminar a probabilidade de mudanças negativas no corpo, impedir o desenvolvimento de complicações graves e efeitos colaterais de drogas. A amostragem bioquímica do material é realizada de manhã, com o estômago vazio, enviado ao laboratório dentro de 2-3 horas.
Semeando material afetado para mídia especial
O método cultural para o diagnóstico de onicomicose é considerado mais preciso. De acordo com os resultados da semeadura, o gênero e o tipo de patógeno, sua concentração é reconhecida. No entanto, o diagnóstico requer mais tempo (de 2 dias a 4 semanas). Para exame, as escamas são coletadas da superfície da placa ungueal e, em seguida, as matérias-primas são observadas. Se colônias características de parasitas se desenvolverem no material biológico analisado, então a amostra será positiva.
Para onde se dirigir
A pesquisa micológica não é realizada de forma alguma em todos os laboratórios, uma vez que o trabalho com esses microrganismos requer equipamento especial, qualificações do pessoal. Raspagem para unha fungo e outros testes relacionados em Moscou são realizadas por centros de micologia para clínicas venéreos e venereological. As policlínicas estatais não fornecem esses serviços, portanto, é melhor entrar em contato com uma clínica particular ou com departamentos bacteriológicos.
Em casa
Na primeira suspeita de infecção por um parasita, o paciente se pergunta como verificar a presença da doença em casa. A medicina alternativa oferece uma maneira fácil de diagnosticar a micose usando permanganato de potássio e água morna. O procedimento de teste é o seguinte:
- Diluir permanganato de potássio em água, atingindo uma cor rosa.
- Segure a unha afetada por 1-3 minutos nesta solução.
- Limpe bem os dedos com uma toalha e avalie as mudanças de cor da lâmina ungueal.
- Tons marrons e amarelos indicam a ausência da doença. A preservação da cor original da unha indica a presença de infecção.

Preço
O custo do teste para a presença de uma infecção fúngica depende do método escolhido, do preço da instituição médica e do período de processamento dos resultados. Em clínicas particulares, o serviço custará mais do que em laboratórios ambulatoriais. Os testes quantitativos custam aos pacientes menos que os qualitativos. Os preços médios dos testes para micose em Moscou são apresentados na tabela:
| Nome da análise | Preço, rublos |
| Raspagem | 700 |
| Baksev com determinação de sensibilidade a drogas | 650 |
| Semeando | 450 |
| Teste PRC de qualidade | 250 |
| Teste quantitativo PRC | 750 |
| Amostra de sangue | 150 |
Video
COGUMELO de unhas. SOSKOB e tratamento prescrito. Fungo de unha nos pés.